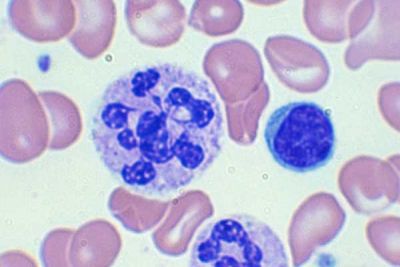
Επίχρισμα περιφερικού αίματος με την χαρακτηριστική μακροκυττάρωση και την υπερκατάτμηση του πυρήνα ενός ουδετερόφιλου

Ο όρος κακοήθης αναιμία (pernicious anemia) γνωστή και ως αναιμία του Addison και Biermer χρησιμοποιείται για μια μορφή μεγαλοβλαστικής αναιμίας που δεν οφείλεται σε ολική γαστρεκτομή αλλά σε ανεπάρκεια του ενδογενή παράγοντα, εξαιτίας αυτοάνοσης ατροφικής γαστρίτιδας, όπου αυτοαντισώματα καταστρέφουν τα γαστρικά τοιχωματικά κύτταρα που τον παράγουν και καθιστούν αδύνατη την δέσμευση της βιταμίνης Β12 απ’ αυτόν.
Επίχρισμα περιφερικού αίματος με την χαρακτηριστική μακροκυττάρωση και την υπερκατάτμηση του πυρήνα ενός ουδετερόφιλου Ο ενδογενής παράγων (Intrinsic factor-IF) είναι μια πρωτεΐνη η οποία εκκρίνεται από τα τοιχωματικά κύτταρα του στομάχου και έχει ρόλο στην δέσμευση (δημιουργία συμπλέγματος) και μεταφορά της βιταμίνης Β12 από το στόμαχο στον ειλεό για να απορροφηθεί και να μεταφερθεί στο αίμα. Η έλλειψη του ενδογενή παράγοντα, και δεδομένου ότι η απορρόφηση από το έντερο της βιταμίνης Β12, εξαρτάται από αυτόν, οδηγεί σε έλλειψη της βιταμίνης B12 στον οργανισμό και ανάπτυξη μεγαλοβλαστικής αναιμίας.
Επίχρισμα περιφερικού αίματος με την χαρακτηριστική μακροκυττάρωση και την υπερκατάτμηση του πυρήνα ενός ουδετερόφιλου Ο ενδογενής παράγων (Intrinsic factor-IF) είναι μια πρωτεΐνη η οποία εκκρίνεται από τα τοιχωματικά κύτταρα του στομάχου και έχει ρόλο στην δέσμευση (δημιουργία συμπλέγματος) και μεταφορά της βιταμίνης Β12 από το στόμαχο στον ειλεό για να απορροφηθεί και να μεταφερθεί στο αίμα. Η έλλειψη του ενδογενή παράγοντα, και δεδομένου ότι η απορρόφηση από το έντερο της βιταμίνης Β12, εξαρτάται από αυτόν, οδηγεί σε έλλειψη της βιταμίνης B12 στον οργανισμό και ανάπτυξη μεγαλοβλαστικής αναιμίας.
Η κακοήθης αναιμία είναι ένα αυτοάνοσο νόσημα που στην παθογένεσή της σημαντικό ρόλο παίζουν ανοσολογικοί μηχανισμοί.
Σε μεγάλο ποσοστό ασθενών (50%) ανευρίσκονται IgG αντισώματα έναντι του ενδογενούς παράγοντα. Τα αντισώματα αυτά είτε παίρνουν τη θέση της βιταμίνης B12, με αποτέλεσμα να μη δημιουργείται το σύμπλεγμα βιταμίνης Β12 και ενδογενούς παράγοντα (B12- IF), είτε δεσμεύουν το σύμπλεγμα «B12- IF» και στη συνέχεια δεν επιτρέπουν την απόδοση της βιταμίνης Β12 στην κυκλοφορία του αίματος δια μέσου του βλεννογόνου του ειλεού.
Σε μεγάλο ποσοστό (80%) ασθενών με κακοήθη αναιμία έχουν βρεθεί αντισώματα έναντι του ενδογενούς παράγοντα στο γαστρικό υγρό. Ο αυτοάνοσος χαρακτήρας της νόσου ενισχύεται από την συνύπαρξη της κακοήθους αναιμίας με άλλα αυτοάνοσα νοσήματα όπως νοσήματα του θυρεοειδούς (νόσος του Graves, θυρεοειδίτιδα Hashimoto) υποπαραθυρεοειδισμό, λεύκη και από την καλή θεραπευτική απάντηση στα κορτικοειδή φάρμακα.
Στην διάγνωση της κακοήθους αναιμίας μπορούν να αναζητηθούν στο ορό του αίματος αντισώματα έναντι του ενδογενούς παράγοντα (βρίσκονται στο 50% των ασθενών) ενώ επισημαίνεται ότι στην κακοήθη αναιμία η άμεσος αντίδραση Coombs είναι θετική σε ποσοστό άνω του 20%, και γίνεται αρνητική σε 2-3 μήνες από την έναρξη της θεραπείας. Η ανεύρεση θετικής αντίδρασης Coombs και αυξημένης χολυρεθρίνης μπορεί να οδηγήσουν σε λανθασμένη διάγνωση αυτοάνοσης αιμολυτικής αναιμίας.